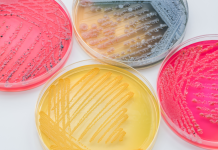
Lenfogranüloma Venereum Nedir?

Orgazm nedir?
Orgazm, cinsel aktivite sırasında meydana gelen yoğun bir zevk hissidir.
Buna bazen gelme ya da doruğa ulaşma denir. Çoğu insanın orgazm olabilir.
Orgazm sırasında ne olur?
Orgazm olduğunuzda kalbiniz daha hızlı atabilir ve nefesiniz değişebilir.
Vajinal veya klitoral bir orgazmınız varsa, cinsel gerginliğin yoğun zevkli bir şekilde salınmasına, genital kasların kasılmaları eşlik eder.
Bazı insanlar vajinal orgazm olduğunda boşalırlar. Yoğun cinsel heyecan veya orgazm sırasında üretraya yakın bezlerden berrak bir sıvı sıçrar. Bezlere Skene bezleri denir.
Bir vajinanız varsa, uyarılmaya devam ederseniz ilkinden kısa bir süre sonra 1’den fazla orgazm yaşayabilirsiniz.
Bir penisiniz varsa, orgazm kasları kasılır ve sperm içeren spermleri penisten çıkarır (boşalma). Bundan sonra, genellikle bir süre başka bir orgazm olamaz.
Penis ve testislerin normal boyutlarına geri döndüğü bu iyileşme aşaması, birkaç dakikadan birkaç saate kadar sürebilir.
Kadınlarda orgazm sorunları ve boşalma sorunları hakkında bilgi edinin.
Kuru Orgazm Nedir?
Kuru orgazm, erkeğin, cinsel doruğa ulaştığında ortaya çıkar, ancak penisinden semen salmaz (boşalmaz) veya çok az miktarda semen salgılar. Semen, sperm taşıyan kalın beyaz sıvıdır.
Kuru orgazm genellikle zararlı değildir, ancak erkeğin çocuk sahibi olma becerisini etkileyebilir. Zamanla, birçok erkek kuru orgazmın normal hissettirdiğini söylüyor.
Kuru Orgazmın Sebepleri Nedir?
Prostat bezinin ve çevresindeki lenf nodlarının (radikal prostatektomi) çıkarılması veya mesanenin çıkarılması (sistektomi) ameliyatının sonucu olarak kuru bir orgazm oluşabilir. Bu işlemlerden herhangi birinden sonra, erkek hasta artık meni üretemeyebilir. Kuru orgazm, orgazmı kontrol eden sinirleri etkileyebilen, retroperitoneal lenf nodu diseksiyonu gibi testis kanseri için yapılan bazı ameliyatlardan sonra da ortaya çıkabilir.
Bazı kuru orgazm vakalarında, meni üretilir ancak cinsel doruk sırasında penisten çıkmak yerine mesaneye gider. Bu retrograd boşalma olarak bilinir ve çoğunlukla tıbbi prosedürlerin, özellikle de bazı prostat ameliyatlarının bir sonucudur. Ayrıca bazı ilaçlar ve sağlık durumlarından da kaynaklanabilir.
Diğer kuru orgazm durumlarında, erkekler üreme sisteminin genetik anormallikleri nedeniyle boşalma için yeterli sperm üretmezler.
Tekrarlanan orgazmlar vücudun tüm taze spermlerini kullanır. Sonuç olarak, tekrarlanan orgazmlardan sonra yaşanan orgazm kuru olabilir. Bu bir alarm nedeni değildir ve genellikle birkaç saat dinlendikten sonra düzelir.
Kuru orgazmın altında yatan nedenler şunlardır:
- Mesane çıkarma ameliyatı (sistektomi)
- Bloke sperm kanalı (boşalma kanalı tıkanması)
- Yüksek tansiyon, genişlemiş prostat ve duygudurum bozukluklarını tedavi etmek için kullanılan bazı ilaçlar
- Şeker hastalığı
- Üreme sisteminin genetik anomalileri
- Erkek hipogonadizmi (testosteron eksikliği)
- Çoklu skleroz
- Açık prostatektomi
- Prostatektomi (radikal)
- Prostat lazer ameliyatı
- Radyasyon tedavisi
- Retrograd boşalma
- Retroperitoneal lenf nodu diseksiyonu
- Omurilik yaralanması
- TUIP (prostatın transüretral insizyonu)
- TUMT (transüretral mikrodalga tedavisi)
- TURP (prostatın transüretral rezeksiyonu)
Kuru Orgazmda Ne Zaman Doktora Gitmeli?
Çoğu durumda, kuru orgazm zararlı değildir. Ancak, durumunuzun, dikkat etmesi gereken bir tıbbi durumdan kaynaklanmadığından emin olmak için doktorunuzla konuşun. Eğer kuru orgazmınız varsa ve partnerinizle çocuk sahibi olmak istiyorsanız, eşinizi hamile bırakmak için tedaviye ihtiyacınız olabilir.
Mayo Clinic, Dry Orgasm, 2018.
- Wein AJ, et al., eds. Disorders of male orgasm and ejaculation. In: Campbell-Walsh Urology. 11th ed. Philadelphia, Pa.: Elsevier; 2016. https://www.clinicalkey.com. Accessed May 29, 2017.
- Cancer can affect a man’s ability to ejaculate. American Cancer Society. https://www.cancer.org/treatment/treatments-and-side-effects/physical-side-effects/fertility-and-sexual-side-effects/sexuality-for-men-with-cancer/ejaculation-and-treatment.html. Accessed May 29, 2017.
- What can cause premature, delayed or dry orgasms? National Health Service. http://www.nhs.uk/chq/Pages/causes-of-ejaculation-problems.aspx. Accessed May 29, 2017.
- Rowland D, et al. Disorders of orgasm and ejaculation in men. The Journal of Sexual Medicine. 2010;7:1668.
- Cunningham GR, et al. Overview of male sexual dysfunction. http://www.uptodate.com/home. Accessed May 29, 2017.
- Frey A, et al. Prevalence and predicting factors for commonly neglected sexual side effects to external-beam radiation therapy for prostate cancer. The Journal of Sexual Medicine. 2017;14:558.
- Hoffman RM, et al. Microwave thermotherapy for benign prostatic hyperplasia. Cochrane Database of Systematic Reviews. http://onlinelibrary.wiley.com/doi/10.1002/14651858.CD004135.pub3/abstract. Accessed May 29, 2017.